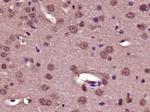
Collagen 1 Antibody in Immunohistochemistry (Paraffin) (IHC (P))

Search
Bioss
Collagen 1 Polyclonal Antibody
{{$productOrderCtrl.translations['antibody.pdp.commerceCard.promotion.promotions']}}
{{$productOrderCtrl.translations['antibody.pdp.commerceCard.promotion.viewpromo']}}
{{$productOrderCtrl.translations['antibody.pdp.commerceCard.promotion.promocode']}}: {{promo.promoCode}} {{promo.promoTitle}} {{promo.promoDescription}}. {{$productOrderCtrl.translations['antibody.pdp.commerceCard.promotion.learnmore']}}
图: 1 / 5
Collagen 1 Antibody (BS-10423R) in IHC (P)

产品信息
BS-10423R
种属反应
宿主/亚型
分类
类型
抗原
偶联物
形式
浓度
纯化类型
保存液
内含物
保存条件
运输条件
靶标信息
Collagen I is a Type I collagen with a triple helix structure comprised of two alpha-1 chains and one alpha-2 chain. Collagen I is a member of group I collagen (fibril-forming collagen) found in most connective tissues, and is abundant in bone, cornea, dermis and tendon. Mutations in the COL1A2 gene encoding the alpha-2 chain are associated with osteogenesis imperfecta types I-IV, Ehlers-Danlos syndrome type VIIB, recessive Ehlers-Danlos syndrome Classical type, idiopathic osteoporosis, and atypical Marfan syndrome. Symptoms associated with mutations in the COL1A2 gene which codes for the alpha-2 chain, however, tend to be less severe than mutations in the COL1A1 gene, reflecting the different role of alpha-2 chains in matrix integrity. Reciprocal translocations between chromosomes 17 and 22, where Collagen Type 1 genes and the gene for platelet derived growth factor beta are located, are associated with a particular type of skin tumor called dermatofibrosarcoma protuberans, resulting from unregulated expression of the growth factor. Two transcripts, resulting from the use of alternate polyadenylation signals, have been identified.
仅用于科研。不用于诊断过程。未经明确授权不得转售。
篇参考文献 (0)
生物信息学
蛋白别名: alpha 1 type I collagen; alpha 2 type I procollagen; alpha 2(I) procollagen; alpha 2(I)-collagen; alpha-1 type 1 collagen; Alpha-1 type I collagen; Alpha-2 type I collagen; alpha1(I) procollagen; COL1; collagen alpha 1 chain type I; Collagen alpha-1(I) chain; collagen alpha-1(I) chain preproprotein; Collagen alpha-2(I) chain; collagen COL1A2; collagen I alpha-2 polypeptide; collagen I, alpha-2 polypeptide; collagen of skin, tendon and bone, alpha-1 chain; collagen of skin, tendon and bone, alpha-2 chain; collagen, type 1, alpha 1; collagen, type I, alpha 1; collagen, type I, alpha 2; osteogenesis imperfecta; prepro-alpha-1 collagen type I; pro-alpha-1 collagen type 1; procollagen type I, alpha 1; procollagen, type 1, alpha 1; procollagen, type I, alpha 1; procollagen, type I, alpha 2; Type I Collagen; type I proalpha 1; type I procollagen; type I procollagen alpha 1 chain; type I-alpha 1 collagen
基因别名: AA960264; AI325291; Col1a-1; Col1a-2; COL1A1; COL1A2; Cola-1; Cola-2; Cola1; Cola2; COLIA1; EDSC; Mov-13; Mov13; OI1; OI2; OI3; OI4; oim
UniProt ID: (Human) P02452, (Human) P08123, (Rat) P02454, (Mouse) P11087, (Mouse) Q01149, (Rat) P02466
Entrez Gene ID: (Human) 1277, (Rabbit) 100347598, (Rabbit) 100008997, (Human) 1278, (Rat) 29393, (Mouse) 12842, (Mouse) 12843, (Rat) 84352



